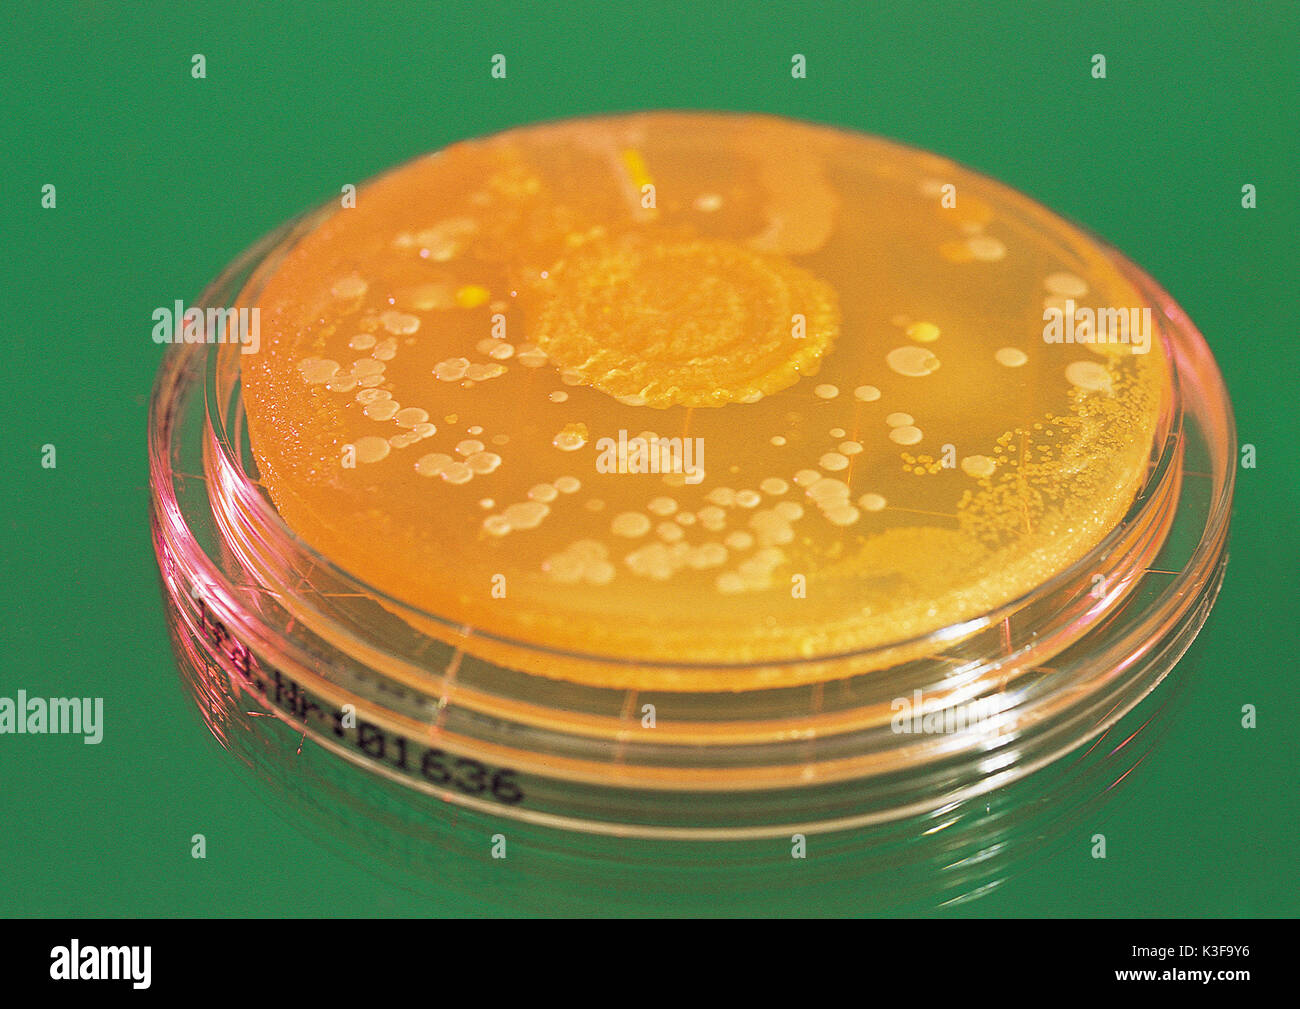
Pilz Kultur auf der Glasscheibe Stockfoto

Schnellfilter:
Auf glas Stockfotos & Bilder
 Kondensation auf Glas Stockfotohttps://www.alamy.de/image-license-details/?v=1https://www.alamy.de/kondensation-auf-glas-image264485932.html
Kondensation auf Glas Stockfotohttps://www.alamy.de/image-license-details/?v=1https://www.alamy.de/kondensation-auf-glas-image264485932.htmlRFWA8AE4–Kondensation auf Glas
 Closeup bunten Textur Wasser kondensiert auf der Glasoberfläche Stockfotohttps://www.alamy.de/image-license-details/?v=1https://www.alamy.de/closeup-bunten-textur-wasser-kondensiert-auf-der-glasoberflache-image639763553.html
Closeup bunten Textur Wasser kondensiert auf der Glasoberfläche Stockfotohttps://www.alamy.de/image-license-details/?v=1https://www.alamy.de/closeup-bunten-textur-wasser-kondensiert-auf-der-glasoberflache-image639763553.htmlRF2S4RMX9–Closeup bunten Textur Wasser kondensiert auf der Glasoberfläche
 Fensterreinigung Fenster Reiniger bei der Arbeit am Glasdach. Reines Wasser Fensterreinigungs-Technologie. Stockfotohttps://www.alamy.de/image-license-details/?v=1https://www.alamy.de/fensterreinigung-fenster-reiniger-bei-der-arbeit-am-glasdach-reines-wasser-fensterreinigungs-technologie-image61259763.html
Fensterreinigung Fenster Reiniger bei der Arbeit am Glasdach. Reines Wasser Fensterreinigungs-Technologie. Stockfotohttps://www.alamy.de/image-license-details/?v=1https://www.alamy.de/fensterreinigung-fenster-reiniger-bei-der-arbeit-am-glasdach-reines-wasser-fensterreinigungs-technologie-image61259763.htmlRMDFJHCK–Fensterreinigung Fenster Reiniger bei der Arbeit am Glasdach. Reines Wasser Fensterreinigungs-Technologie.
 Junge Lösung Puzzle auf Glastisch im Wohnzimmer zu Hause Stockfotohttps://www.alamy.de/image-license-details/?v=1https://www.alamy.de/stockfoto-junge-losung-puzzle-auf-glastisch-im-wohnzimmer-zu-hause-73371577.html
Junge Lösung Puzzle auf Glastisch im Wohnzimmer zu Hause Stockfotohttps://www.alamy.de/image-license-details/?v=1https://www.alamy.de/stockfoto-junge-losung-puzzle-auf-glastisch-im-wohnzimmer-zu-hause-73371577.htmlRFE7AA5D–Junge Lösung Puzzle auf Glastisch im Wohnzimmer zu Hause
 Wolken spiegeln sich auf Glas außen Stockfotohttps://www.alamy.de/image-license-details/?v=1https://www.alamy.de/wolken-spiegeln-sich-auf-glas-aussen-image345112904.html
Wolken spiegeln sich auf Glas außen Stockfotohttps://www.alamy.de/image-license-details/?v=1https://www.alamy.de/wolken-spiegeln-sich-auf-glas-aussen-image345112904.htmlRF2B1D70T–Wolken spiegeln sich auf Glas außen
 Regen Sie Tropfen auf Glas-Fenster-Hintergrund mit weißen und gelben Sie Plumeria Blume auf alten Holztisch. Stockfotohttps://www.alamy.de/image-license-details/?v=1https://www.alamy.de/stockfoto-regen-sie-tropfen-auf-glas-fenster-hintergrund-mit-weissen-und-gelben-sie-plumeria-blume-auf-alten-holztisch-120458422.html
Regen Sie Tropfen auf Glas-Fenster-Hintergrund mit weißen und gelben Sie Plumeria Blume auf alten Holztisch. Stockfotohttps://www.alamy.de/image-license-details/?v=1https://www.alamy.de/stockfoto-regen-sie-tropfen-auf-glas-fenster-hintergrund-mit-weissen-und-gelben-sie-plumeria-blume-auf-alten-holztisch-120458422.htmlRFGYY9XE–Regen Sie Tropfen auf Glas-Fenster-Hintergrund mit weißen und gelben Sie Plumeria Blume auf alten Holztisch.
 Queens, New York, neue Bürogebäude in Long Island City fotografiert durch auf Glas regnete Stockfotohttps://www.alamy.de/image-license-details/?v=1https://www.alamy.de/stockfoto-queens-new-york-neue-burogebaude-in-long-island-city-fotografiert-durch-auf-glas-regnete-164852400.html
Queens, New York, neue Bürogebäude in Long Island City fotografiert durch auf Glas regnete Stockfotohttps://www.alamy.de/image-license-details/?v=1https://www.alamy.de/stockfoto-queens-new-york-neue-burogebaude-in-long-island-city-fotografiert-durch-auf-glas-regnete-164852400.htmlRMKG5JWM–Queens, New York, neue Bürogebäude in Long Island City fotografiert durch auf Glas regnete
 City of London England, UK Ludgate Hill, St Paul's Cathedral, Mutterkirche, Anglikaner, Religion, historisch, Grade I aufgeführt, Kuppel, Spiegelreflexion auf Glas, Großbritannien Stockfotohttps://www.alamy.de/image-license-details/?v=1https://www.alamy.de/city-of-london-england-uk-ludgate-hill-st-pauls-cathedral-mutterkirche-anglikaner-religion-historisch-grade-i-aufgefuhrt-kuppel-spiegelreflexion-auf-glas-grossbritannien-image226076327.html
City of London England, UK Ludgate Hill, St Paul's Cathedral, Mutterkirche, Anglikaner, Religion, historisch, Grade I aufgeführt, Kuppel, Spiegelreflexion auf Glas, Großbritannien Stockfotohttps://www.alamy.de/image-license-details/?v=1https://www.alamy.de/city-of-london-england-uk-ludgate-hill-st-pauls-cathedral-mutterkirche-anglikaner-religion-historisch-grade-i-aufgefuhrt-kuppel-spiegelreflexion-auf-glas-grossbritannien-image226076327.htmlRMR3PJJF–City of London England, UK Ludgate Hill, St Paul's Cathedral, Mutterkirche, Anglikaner, Religion, historisch, Grade I aufgeführt, Kuppel, Spiegelreflexion auf Glas, Großbritannien
 Nahaufnahme von ein paar Murmeln auf Glastisch Stockfotohttps://www.alamy.de/image-license-details/?v=1https://www.alamy.de/stockfoto-nahaufnahme-von-ein-paar-murmeln-auf-glastisch-124348732.html
Nahaufnahme von ein paar Murmeln auf Glastisch Stockfotohttps://www.alamy.de/image-license-details/?v=1https://www.alamy.de/stockfoto-nahaufnahme-von-ein-paar-murmeln-auf-glastisch-124348732.htmlRFH68G24–Nahaufnahme von ein paar Murmeln auf Glastisch
 Tauben auf dem Glasdach des St Enoch Station, Glasgow, Schottland, Großbritannien Stockfotohttps://www.alamy.de/image-license-details/?v=1https://www.alamy.de/tauben-auf-dem-glasdach-des-st-enoch-station-glasgow-schottland-grossbritannien-image185533292.html
Tauben auf dem Glasdach des St Enoch Station, Glasgow, Schottland, Großbritannien Stockfotohttps://www.alamy.de/image-license-details/?v=1https://www.alamy.de/tauben-auf-dem-glasdach-des-st-enoch-station-glasgow-schottland-grossbritannien-image185533292.htmlRFMNRNH0–Tauben auf dem Glasdach des St Enoch Station, Glasgow, Schottland, Großbritannien
 Junge Frau stützte sich auf Glaswand und Text-messaging Stockfotohttps://www.alamy.de/image-license-details/?v=1https://www.alamy.de/stockfoto-junge-frau-stutzte-sich-auf-glaswand-und-text-messaging-132930383.html
Junge Frau stützte sich auf Glaswand und Text-messaging Stockfotohttps://www.alamy.de/image-license-details/?v=1https://www.alamy.de/stockfoto-junge-frau-stutzte-sich-auf-glaswand-und-text-messaging-132930383.htmlRFHM7E1K–Junge Frau stützte sich auf Glaswand und Text-messaging
 Wassertropfen auf einem Auto Spiegel, Reflexion auf Glas mit Regentropfen Stockfotohttps://www.alamy.de/image-license-details/?v=1https://www.alamy.de/wassertropfen-auf-einem-auto-spiegel-reflexion-auf-glas-mit-regentropfen-image234676401.html
Wassertropfen auf einem Auto Spiegel, Reflexion auf Glas mit Regentropfen Stockfotohttps://www.alamy.de/image-license-details/?v=1https://www.alamy.de/wassertropfen-auf-einem-auto-spiegel-reflexion-auf-glas-mit-regentropfen-image234676401.htmlRFRHPC41–Wassertropfen auf einem Auto Spiegel, Reflexion auf Glas mit Regentropfen
 Wassertropfen auf Glas hautnah Stockfotohttps://www.alamy.de/image-license-details/?v=1https://www.alamy.de/stockfoto-wassertropfen-auf-glas-hautnah-86172117.html
Wassertropfen auf Glas hautnah Stockfotohttps://www.alamy.de/image-license-details/?v=1https://www.alamy.de/stockfoto-wassertropfen-auf-glas-hautnah-86172117.htmlRFF05DBH–Wassertropfen auf Glas hautnah
 Weiblichen Kollegen kleben Klebefuge Notizen auf Glas Stockfotohttps://www.alamy.de/image-license-details/?v=1https://www.alamy.de/weiblichen-kollegen-kleben-klebefuge-notizen-auf-glas-image61873712.html
Weiblichen Kollegen kleben Klebefuge Notizen auf Glas Stockfotohttps://www.alamy.de/image-license-details/?v=1https://www.alamy.de/weiblichen-kollegen-kleben-klebefuge-notizen-auf-glas-image61873712.htmlRFDGJGFC–Weiblichen Kollegen kleben Klebefuge Notizen auf Glas
 Mohn- Plätzchen auf Glas Kuchen stehen an Weihnachten Stockfotohttps://www.alamy.de/image-license-details/?v=1https://www.alamy.de/stockfoto-mohn-platzchen-auf-glas-kuchen-stehen-an-weihnachten-175574532.html
Mohn- Plätzchen auf Glas Kuchen stehen an Weihnachten Stockfotohttps://www.alamy.de/image-license-details/?v=1https://www.alamy.de/stockfoto-mohn-platzchen-auf-glas-kuchen-stehen-an-weihnachten-175574532.htmlRFM5J330–Mohn- Plätzchen auf Glas Kuchen stehen an Weihnachten
 Regenwasser fällt auf Glas über verschwommenen blauen Hintergrund, abstraktes Texturmuster Stockfotohttps://www.alamy.de/image-license-details/?v=1https://www.alamy.de/regenwasser-fallt-auf-glas-uber-verschwommenen-blauen-hintergrund-abstraktes-texturmuster-image350558298.html
Regenwasser fällt auf Glas über verschwommenen blauen Hintergrund, abstraktes Texturmuster Stockfotohttps://www.alamy.de/image-license-details/?v=1https://www.alamy.de/regenwasser-fallt-auf-glas-uber-verschwommenen-blauen-hintergrund-abstraktes-texturmuster-image350558298.htmlRF2BA98K6–Regenwasser fällt auf Glas über verschwommenen blauen Hintergrund, abstraktes Texturmuster
 Tropfen Sie Wasser für den Hintergrund auf Glas Autofenster zu abstrakten Design und Natur-Kulisse. Stockfotohttps://www.alamy.de/image-license-details/?v=1https://www.alamy.de/stockfoto-tropfen-sie-wasser-fur-den-hintergrund-auf-glas-autofenster-zu-abstrakten-design-und-natur-kulisse-113606050.html
Tropfen Sie Wasser für den Hintergrund auf Glas Autofenster zu abstrakten Design und Natur-Kulisse. Stockfotohttps://www.alamy.de/image-license-details/?v=1https://www.alamy.de/stockfoto-tropfen-sie-wasser-fur-den-hintergrund-auf-glas-autofenster-zu-abstrakten-design-und-natur-kulisse-113606050.htmlRFGGR5JX–Tropfen Sie Wasser für den Hintergrund auf Glas Autofenster zu abstrakten Design und Natur-Kulisse.
 Frisch gebackene Schokoladenkekse auf Glas Etagere mit zwei Cookies auf einem Teller. Querformat. Natürliches Licht Stockfotohttps://www.alamy.de/image-license-details/?v=1https://www.alamy.de/stockfoto-frisch-gebackene-schokoladenkekse-auf-glas-etagere-mit-zwei-cookies-auf-einem-teller-querformat-naturliches-licht-123749392.html
Frisch gebackene Schokoladenkekse auf Glas Etagere mit zwei Cookies auf einem Teller. Querformat. Natürliches Licht Stockfotohttps://www.alamy.de/image-license-details/?v=1https://www.alamy.de/stockfoto-frisch-gebackene-schokoladenkekse-auf-glas-etagere-mit-zwei-cookies-auf-einem-teller-querformat-naturliches-licht-123749392.htmlRFH597H4–Frisch gebackene Schokoladenkekse auf Glas Etagere mit zwei Cookies auf einem Teller. Querformat. Natürliches Licht
 Regen auf Glasscheibe schöne Bokeh an einem Flughafen genommen Stockfotohttps://www.alamy.de/image-license-details/?v=1https://www.alamy.de/regen-auf-glasscheibe-schone-bokeh-an-einem-flughafen-genommen-image263374275.html
Regen auf Glasscheibe schöne Bokeh an einem Flughafen genommen Stockfotohttps://www.alamy.de/image-license-details/?v=1https://www.alamy.de/regen-auf-glasscheibe-schone-bokeh-an-einem-flughafen-genommen-image263374275.htmlRFW8DMG3–Regen auf Glasscheibe schöne Bokeh an einem Flughafen genommen
 Regen Sie auf Glas roten Gebäude abstrakte Boot Fenster Alaska Inside Passage Southeast Alaska USA Stockfotohttps://www.alamy.de/image-license-details/?v=1https://www.alamy.de/stockfoto-regen-sie-auf-glas-roten-gebaude-abstrakte-boot-fenster-alaska-inside-passage-southeast-alaska-usa-116845335.html
Regen Sie auf Glas roten Gebäude abstrakte Boot Fenster Alaska Inside Passage Southeast Alaska USA Stockfotohttps://www.alamy.de/image-license-details/?v=1https://www.alamy.de/stockfoto-regen-sie-auf-glas-roten-gebaude-abstrakte-boot-fenster-alaska-inside-passage-southeast-alaska-usa-116845335.htmlRMGP2NBK–Regen Sie auf Glas roten Gebäude abstrakte Boot Fenster Alaska Inside Passage Southeast Alaska USA
 Closeup getönten Textur Wasser kondensiert auf der Glasoberfläche Stockfotohttps://www.alamy.de/image-license-details/?v=1https://www.alamy.de/closeup-getonten-textur-wasser-kondensiert-auf-der-glasoberflache-image639763963.html
Closeup getönten Textur Wasser kondensiert auf der Glasoberfläche Stockfotohttps://www.alamy.de/image-license-details/?v=1https://www.alamy.de/closeup-getonten-textur-wasser-kondensiert-auf-der-glasoberflache-image639763963.htmlRF2S4RNCY–Closeup getönten Textur Wasser kondensiert auf der Glasoberfläche
 Schöne farbige Beugungseffekte von Wassertröpfchen auf Glas gegen Ein mehrfarbiger Hintergrund Stockfotohttps://www.alamy.de/image-license-details/?v=1https://www.alamy.de/schone-farbige-beugungseffekte-von-wassertropfchen-auf-glas-gegen-ein-mehrfarbiger-hintergrund-image425758695.html
Schöne farbige Beugungseffekte von Wassertröpfchen auf Glas gegen Ein mehrfarbiger Hintergrund Stockfotohttps://www.alamy.de/image-license-details/?v=1https://www.alamy.de/schone-farbige-beugungseffekte-von-wassertropfchen-auf-glas-gegen-ein-mehrfarbiger-hintergrund-image425758695.htmlRF2FMJYFK–Schöne farbige Beugungseffekte von Wassertröpfchen auf Glas gegen Ein mehrfarbiger Hintergrund
 Gekritzel auf Glasfenster Stockfotohttps://www.alamy.de/image-license-details/?v=1https://www.alamy.de/stockfoto-gekritzel-auf-glasfenster-83163283.html
Gekritzel auf Glasfenster Stockfotohttps://www.alamy.de/image-license-details/?v=1https://www.alamy.de/stockfoto-gekritzel-auf-glasfenster-83163283.htmlRFER8BH7–Gekritzel auf Glasfenster
 Zeichen für Polizei auf Glas Fenster der Polizeistation Stockfotohttps://www.alamy.de/image-license-details/?v=1https://www.alamy.de/stockfoto-zeichen-fur-polizei-auf-glas-fenster-der-polizeistation-166177964.html
Zeichen für Polizei auf Glas Fenster der Polizeistation Stockfotohttps://www.alamy.de/image-license-details/?v=1https://www.alamy.de/stockfoto-zeichen-fur-polizei-auf-glas-fenster-der-polizeistation-166177964.htmlRMKJA1K8–Zeichen für Polizei auf Glas Fenster der Polizeistation
 Geschnittene Gemüse Anzeige auf Glasschale auf weißes Tuch Hintergrund Stockfotohttps://www.alamy.de/image-license-details/?v=1https://www.alamy.de/stockfoto-geschnittene-gemuse-anzeige-auf-glasschale-auf-weisses-tuch-hintergrund-56880777.html
Geschnittene Gemüse Anzeige auf Glasschale auf weißes Tuch Hintergrund Stockfotohttps://www.alamy.de/image-license-details/?v=1https://www.alamy.de/stockfoto-geschnittene-gemuse-anzeige-auf-glasschale-auf-weisses-tuch-hintergrund-56880777.htmlRFD8F409–Geschnittene Gemüse Anzeige auf Glasschale auf weißes Tuch Hintergrund
 Dunkel blaue Vorhänge auf Glas Terrassentüren im spanischen Villa Schlafzimmer mit Tür, Sitzecke Stockfotohttps://www.alamy.de/image-license-details/?v=1https://www.alamy.de/stockfoto-dunkel-blaue-vorhange-auf-glas-terrassenturen-im-spanischen-villa-schlafzimmer-mit-tur-sitzecke-87851656.html
Dunkel blaue Vorhänge auf Glas Terrassentüren im spanischen Villa Schlafzimmer mit Tür, Sitzecke Stockfotohttps://www.alamy.de/image-license-details/?v=1https://www.alamy.de/stockfoto-dunkel-blaue-vorhange-auf-glas-terrassenturen-im-spanischen-villa-schlafzimmer-mit-tur-sitzecke-87851656.htmlRFF2WYK4–Dunkel blaue Vorhänge auf Glas Terrassentüren im spanischen Villa Schlafzimmer mit Tür, Sitzecke
Pilz Kultur auf der Glasscheibe Stockfotohttps://www.alamy.de/image-license-details/?v=1https://www.alamy.de/pilz-kultur-auf-der-glasscheibe-image157074378.html
Pilz Kultur auf der Glasscheibe Stockfotohttps://www.alamy.de/image-license-details/?v=1https://www.alamy.de/pilz-kultur-auf-der-glasscheibe-image157074378.htmlRFK3F9Y6–Pilz Kultur auf der Glasscheibe
 Drei Eiswürfel auf Glas Hintergrund Stockfotohttps://www.alamy.de/image-license-details/?v=1https://www.alamy.de/stockfoto-drei-eiswurfel-auf-glas-hintergrund-112978448.html
Drei Eiswürfel auf Glas Hintergrund Stockfotohttps://www.alamy.de/image-license-details/?v=1https://www.alamy.de/stockfoto-drei-eiswurfel-auf-glas-hintergrund-112978448.htmlRFGFPH4G–Drei Eiswürfel auf Glas Hintergrund
 Bundesnetzagentur, Logo mit Bundesadler auf Glas Stockfotohttps://www.alamy.de/image-license-details/?v=1https://www.alamy.de/stockfoto-bundesnetzagentur-logo-mit-bundesadler-auf-glas-117679403.html
Bundesnetzagentur, Logo mit Bundesadler auf Glas Stockfotohttps://www.alamy.de/image-license-details/?v=1https://www.alamy.de/stockfoto-bundesnetzagentur-logo-mit-bundesadler-auf-glas-117679403.htmlRMGRCN7R–Bundesnetzagentur, Logo mit Bundesadler auf Glas
 Regentropfen auf Glas Stockfotohttps://www.alamy.de/image-license-details/?v=1https://www.alamy.de/stockfoto-regentropfen-auf-glas-98027374.html
Regentropfen auf Glas Stockfotohttps://www.alamy.de/image-license-details/?v=1https://www.alamy.de/stockfoto-regentropfen-auf-glas-98027374.htmlRFFKDEWJ–Regentropfen auf Glas
 Man schreibt auf Glasplatte oder arbeiten mit virtuellen Bildschirm, kleinen dof Stockfotohttps://www.alamy.de/image-license-details/?v=1https://www.alamy.de/stockfoto-man-schreibt-auf-glasplatte-oder-arbeiten-mit-virtuellen-bildschirm-kleinen-dof-57669846.html
Man schreibt auf Glasplatte oder arbeiten mit virtuellen Bildschirm, kleinen dof Stockfotohttps://www.alamy.de/image-license-details/?v=1https://www.alamy.de/stockfoto-man-schreibt-auf-glasplatte-oder-arbeiten-mit-virtuellen-bildschirm-kleinen-dof-57669846.htmlRFD9R2DA–Man schreibt auf Glasplatte oder arbeiten mit virtuellen Bildschirm, kleinen dof
 Textur des Eises auf Glas Stockfotohttps://www.alamy.de/image-license-details/?v=1https://www.alamy.de/textur-des-eises-auf-glas-image66462443.html
Textur des Eises auf Glas Stockfotohttps://www.alamy.de/image-license-details/?v=1https://www.alamy.de/textur-des-eises-auf-glas-image66462443.htmlRFDT3HEK–Textur des Eises auf Glas
 Junger Mann mit Handy, während er sich an einer Glaswand lehnte Stockfotohttps://www.alamy.de/image-license-details/?v=1https://www.alamy.de/junger-mann-mit-handy-wahrend-er-sich-an-einer-glaswand-lehnte-image389285460.html
Junger Mann mit Handy, während er sich an einer Glaswand lehnte Stockfotohttps://www.alamy.de/image-license-details/?v=1https://www.alamy.de/junger-mann-mit-handy-wahrend-er-sich-an-einer-glaswand-lehnte-image389285460.htmlRF2DH9DG4–Junger Mann mit Handy, während er sich an einer Glaswand lehnte
 Porträt der jungen Geschäftsfrau schreiben auf Glasscheibe Stockfotohttps://www.alamy.de/image-license-details/?v=1https://www.alamy.de/portrat-der-jungen-geschaftsfrau-schreiben-auf-glasscheibe-image260984362.html
Porträt der jungen Geschäftsfrau schreiben auf Glasscheibe Stockfotohttps://www.alamy.de/image-license-details/?v=1https://www.alamy.de/portrat-der-jungen-geschaftsfrau-schreiben-auf-glasscheibe-image260984362.htmlRFW4GT62–Porträt der jungen Geschäftsfrau schreiben auf Glasscheibe
 Regenwasser fällt auf Glas über verwacklungsunscharfen silbernen Hintergrund, abstraktes Texturmuster Stockfotohttps://www.alamy.de/image-license-details/?v=1https://www.alamy.de/regenwasser-fallt-auf-glas-uber-verwacklungsunscharfen-silbernen-hintergrund-abstraktes-texturmuster-image350598885.html
Regenwasser fällt auf Glas über verwacklungsunscharfen silbernen Hintergrund, abstraktes Texturmuster Stockfotohttps://www.alamy.de/image-license-details/?v=1https://www.alamy.de/regenwasser-fallt-auf-glas-uber-verwacklungsunscharfen-silbernen-hintergrund-abstraktes-texturmuster-image350598885.htmlRF2BAB4CN–Regenwasser fällt auf Glas über verwacklungsunscharfen silbernen Hintergrund, abstraktes Texturmuster
 Tropfen Sie Wasser für den Hintergrund auf Glas Autofenster zu abstrakten Design und Natur-Kulisse. Stockfotohttps://www.alamy.de/image-license-details/?v=1https://www.alamy.de/stockfoto-tropfen-sie-wasser-fur-den-hintergrund-auf-glas-autofenster-zu-abstrakten-design-und-natur-kulisse-113545202.html
Tropfen Sie Wasser für den Hintergrund auf Glas Autofenster zu abstrakten Design und Natur-Kulisse. Stockfotohttps://www.alamy.de/image-license-details/?v=1https://www.alamy.de/stockfoto-tropfen-sie-wasser-fur-den-hintergrund-auf-glas-autofenster-zu-abstrakten-design-und-natur-kulisse-113545202.htmlRFGGMC1P–Tropfen Sie Wasser für den Hintergrund auf Glas Autofenster zu abstrakten Design und Natur-Kulisse.
 Wissenschaftler schreiben wissenschaftliche Symbole auf Glas Stockfotohttps://www.alamy.de/image-license-details/?v=1https://www.alamy.de/stockfoto-wissenschaftler-schreiben-wissenschaftliche-symbole-auf-glas-58090299.html
Wissenschaftler schreiben wissenschaftliche Symbole auf Glas Stockfotohttps://www.alamy.de/image-license-details/?v=1https://www.alamy.de/stockfoto-wissenschaftler-schreiben-wissenschaftliche-symbole-auf-glas-58090299.htmlRFDAE6NF–Wissenschaftler schreiben wissenschaftliche Symbole auf Glas
 Kaukasische Geschäftsfrau Glasfenster Diagramm anhand Stockfotohttps://www.alamy.de/image-license-details/?v=1https://www.alamy.de/stockfoto-kaukasische-geschaftsfrau-glasfenster-diagramm-anhand-135936368.html
Kaukasische Geschäftsfrau Glasfenster Diagramm anhand Stockfotohttps://www.alamy.de/image-license-details/?v=1https://www.alamy.de/stockfoto-kaukasische-geschaftsfrau-glasfenster-diagramm-anhand-135936368.htmlRFHW4C68–Kaukasische Geschäftsfrau Glasfenster Diagramm anhand
 Regen Sie auf Glas roten Gebäude abstrakte Boot Fenster Alaska Inside Passage Southeast Alaska USA Stockfotohttps://www.alamy.de/image-license-details/?v=1https://www.alamy.de/stockfoto-regen-sie-auf-glas-roten-gebaude-abstrakte-boot-fenster-alaska-inside-passage-southeast-alaska-usa-116845324.html
Regen Sie auf Glas roten Gebäude abstrakte Boot Fenster Alaska Inside Passage Southeast Alaska USA Stockfotohttps://www.alamy.de/image-license-details/?v=1https://www.alamy.de/stockfoto-regen-sie-auf-glas-roten-gebaude-abstrakte-boot-fenster-alaska-inside-passage-southeast-alaska-usa-116845324.htmlRMGP2NB8–Regen Sie auf Glas roten Gebäude abstrakte Boot Fenster Alaska Inside Passage Southeast Alaska USA
 Regentropfen auf Glasfenster mit Stadtbild Hintergrund Stockfotohttps://www.alamy.de/image-license-details/?v=1https://www.alamy.de/regentropfen-auf-glasfenster-mit-stadtbild-hintergrund-image639731188.html
Regentropfen auf Glasfenster mit Stadtbild Hintergrund Stockfotohttps://www.alamy.de/image-license-details/?v=1https://www.alamy.de/regentropfen-auf-glasfenster-mit-stadtbild-hintergrund-image639731188.htmlRF2S4P7JC–Regentropfen auf Glasfenster mit Stadtbild Hintergrund
 Schöne farbige Beugungseffekte von Wassertröpfchen auf Glas gegen Ein mehrfarbiger Hintergrund Stockfotohttps://www.alamy.de/image-license-details/?v=1https://www.alamy.de/schone-farbige-beugungseffekte-von-wassertropfchen-auf-glas-gegen-ein-mehrfarbiger-hintergrund-image425758700.html
Schöne farbige Beugungseffekte von Wassertröpfchen auf Glas gegen Ein mehrfarbiger Hintergrund Stockfotohttps://www.alamy.de/image-license-details/?v=1https://www.alamy.de/schone-farbige-beugungseffekte-von-wassertropfchen-auf-glas-gegen-ein-mehrfarbiger-hintergrund-image425758700.htmlRF2FMJYFT–Schöne farbige Beugungseffekte von Wassertröpfchen auf Glas gegen Ein mehrfarbiger Hintergrund
 Reflexion von Haarbürsten in der Luft auf Glastisch Stockfotohttps://www.alamy.de/image-license-details/?v=1https://www.alamy.de/stockfoto-reflexion-von-haarbursten-in-der-luft-auf-glastisch-102672334.html
Reflexion von Haarbürsten in der Luft auf Glastisch Stockfotohttps://www.alamy.de/image-license-details/?v=1https://www.alamy.de/stockfoto-reflexion-von-haarbursten-in-der-luft-auf-glastisch-102672334.htmlRFFY13H2–Reflexion von Haarbürsten in der Luft auf Glastisch
 Geschäftsmann zeichnen einen leeren Flussdiagramm auf Glas Stockfotohttps://www.alamy.de/image-license-details/?v=1https://www.alamy.de/stockfoto-geschaftsmann-zeichnen-einen-leeren-flussdiagramm-auf-glas-134307209.html
Geschäftsmann zeichnen einen leeren Flussdiagramm auf Glas Stockfotohttps://www.alamy.de/image-license-details/?v=1https://www.alamy.de/stockfoto-geschaftsmann-zeichnen-einen-leeren-flussdiagramm-auf-glas-134307209.htmlRFHPE661–Geschäftsmann zeichnen einen leeren Flussdiagramm auf Glas
 Kondensation auf Glas Eingangstüren von Shop in St Johns Town Center Jacksonville Florida USA Das Kondenswasser wird durch den Unterschied in der Uhr verursacht Stockfotohttps://www.alamy.de/image-license-details/?v=1https://www.alamy.de/kondensation-auf-glas-eingangsturen-von-shop-in-st-johns-town-center-jacksonville-florida-usa-das-kondenswasser-wird-durch-den-unterschied-in-der-uhr-verursacht-image259498245.html
Kondensation auf Glas Eingangstüren von Shop in St Johns Town Center Jacksonville Florida USA Das Kondenswasser wird durch den Unterschied in der Uhr verursacht Stockfotohttps://www.alamy.de/image-license-details/?v=1https://www.alamy.de/kondensation-auf-glas-eingangsturen-von-shop-in-st-johns-town-center-jacksonville-florida-usa-das-kondenswasser-wird-durch-den-unterschied-in-der-uhr-verursacht-image259498245.htmlRMW254JD–Kondensation auf Glas Eingangstüren von Shop in St Johns Town Center Jacksonville Florida USA Das Kondenswasser wird durch den Unterschied in der Uhr verursacht
 Shanghai The Bund mit Reflexion auf Glas Stockfotohttps://www.alamy.de/image-license-details/?v=1https://www.alamy.de/shanghai-the-bund-mit-reflexion-auf-glas-image217440659.html
Shanghai The Bund mit Reflexion auf Glas Stockfotohttps://www.alamy.de/image-license-details/?v=1https://www.alamy.de/shanghai-the-bund-mit-reflexion-auf-glas-image217440659.htmlRMPHN7NR–Shanghai The Bund mit Reflexion auf Glas
 Mädchen mit einem Milch-Schnurrbart, stützte sich auf Glastisch Glas Milch Stockfotohttps://www.alamy.de/image-license-details/?v=1https://www.alamy.de/stockfoto-madchen-mit-einem-milch-schnurrbart-stutzte-sich-auf-glastisch-glas-milch-76841207.html
Mädchen mit einem Milch-Schnurrbart, stützte sich auf Glastisch Glas Milch Stockfotohttps://www.alamy.de/image-license-details/?v=1https://www.alamy.de/stockfoto-madchen-mit-einem-milch-schnurrbart-stutzte-sich-auf-glastisch-glas-milch-76841207.htmlRFED0BMR–Mädchen mit einem Milch-Schnurrbart, stützte sich auf Glastisch Glas Milch
 Wassertropfen auf der Glasoberfläche Stockfotohttps://www.alamy.de/image-license-details/?v=1https://www.alamy.de/wassertropfen-auf-der-glasoberflache-image64099455.html
Wassertropfen auf der Glasoberfläche Stockfotohttps://www.alamy.de/image-license-details/?v=1https://www.alamy.de/wassertropfen-auf-der-glasoberflache-image64099455.htmlRMDM7YE7–Wassertropfen auf der Glasoberfläche
 Fisch saugt auf Glas Stockfotohttps://www.alamy.de/image-license-details/?v=1https://www.alamy.de/fisch-saugt-auf-glas-image362932836.html
Fisch saugt auf Glas Stockfotohttps://www.alamy.de/image-license-details/?v=1https://www.alamy.de/fisch-saugt-auf-glas-image362932836.htmlRF2C2D0F0–Fisch saugt auf Glas
 Laptop auf Glastisch Stockfotohttps://www.alamy.de/image-license-details/?v=1https://www.alamy.de/stockfoto-laptop-auf-glastisch-92836474.html
Laptop auf Glastisch Stockfotohttps://www.alamy.de/image-license-details/?v=1https://www.alamy.de/stockfoto-laptop-auf-glastisch-92836474.htmlRFFB11TA–Laptop auf Glastisch
 Man schreibt auf Glasplatte oder arbeiten mit virtuellen Bildschirm, kleinen dof Stockfotohttps://www.alamy.de/image-license-details/?v=1https://www.alamy.de/stockfoto-man-schreibt-auf-glasplatte-oder-arbeiten-mit-virtuellen-bildschirm-kleinen-dof-57669848.html
Man schreibt auf Glasplatte oder arbeiten mit virtuellen Bildschirm, kleinen dof Stockfotohttps://www.alamy.de/image-license-details/?v=1https://www.alamy.de/stockfoto-man-schreibt-auf-glasplatte-oder-arbeiten-mit-virtuellen-bildschirm-kleinen-dof-57669848.htmlRFD9R2DC–Man schreibt auf Glasplatte oder arbeiten mit virtuellen Bildschirm, kleinen dof
 Textur des Eises auf Glas Stockfotohttps://www.alamy.de/image-license-details/?v=1https://www.alamy.de/textur-des-eises-auf-glas-image66462629.html
Textur des Eises auf Glas Stockfotohttps://www.alamy.de/image-license-details/?v=1https://www.alamy.de/textur-des-eises-auf-glas-image66462629.htmlRFDT3HN9–Textur des Eises auf Glas
 Porträt des Unternehmers lehnt auf Glasfenster im Büro Stockfotohttps://www.alamy.de/image-license-details/?v=1https://www.alamy.de/portrat-des-unternehmers-lehnt-auf-glasfenster-im-buro-image389271474.html
Porträt des Unternehmers lehnt auf Glasfenster im Büro Stockfotohttps://www.alamy.de/image-license-details/?v=1https://www.alamy.de/portrat-des-unternehmers-lehnt-auf-glasfenster-im-buro-image389271474.htmlRF2DH8RMJ–Porträt des Unternehmers lehnt auf Glasfenster im Büro
 Geschäftsfrau Brainstorming mit Post-its auf der Glasscheibe Stockfotohttps://www.alamy.de/image-license-details/?v=1https://www.alamy.de/geschaftsfrau-brainstorming-mit-post-its-auf-der-glasscheibe-image257036444.html
Geschäftsfrau Brainstorming mit Post-its auf der Glasscheibe Stockfotohttps://www.alamy.de/image-license-details/?v=1https://www.alamy.de/geschaftsfrau-brainstorming-mit-post-its-auf-der-glasscheibe-image257036444.htmlRFTX50H0–Geschäftsfrau Brainstorming mit Post-its auf der Glasscheibe
 Regentropfen auf Glas Stockfotohttps://www.alamy.de/image-license-details/?v=1https://www.alamy.de/regentropfen-auf-glas-image367375495.html
Regentropfen auf Glas Stockfotohttps://www.alamy.de/image-license-details/?v=1https://www.alamy.de/regentropfen-auf-glas-image367375495.htmlRF2C9KB5B–Regentropfen auf Glas
 Tropfen Sie Wasser für den Hintergrund auf Glas Autofenster zu abstrakten Design und Natur-Kulisse. Stockfotohttps://www.alamy.de/image-license-details/?v=1https://www.alamy.de/stockfoto-tropfen-sie-wasser-fur-den-hintergrund-auf-glas-autofenster-zu-abstrakten-design-und-natur-kulisse-113606049.html
Tropfen Sie Wasser für den Hintergrund auf Glas Autofenster zu abstrakten Design und Natur-Kulisse. Stockfotohttps://www.alamy.de/image-license-details/?v=1https://www.alamy.de/stockfoto-tropfen-sie-wasser-fur-den-hintergrund-auf-glas-autofenster-zu-abstrakten-design-und-natur-kulisse-113606049.htmlRFGGR5JW–Tropfen Sie Wasser für den Hintergrund auf Glas Autofenster zu abstrakten Design und Natur-Kulisse.
 Wassertropfen auf Glas Stockfotohttps://www.alamy.de/image-license-details/?v=1https://www.alamy.de/stockfoto-wassertropfen-auf-glas-82187123.html
Wassertropfen auf Glas Stockfotohttps://www.alamy.de/image-license-details/?v=1https://www.alamy.de/stockfoto-wassertropfen-auf-glas-82187123.htmlRFENKXEB–Wassertropfen auf Glas
 Öl verschmiert auf Glas mit blauem Hintergrund Stockfotohttps://www.alamy.de/image-license-details/?v=1https://www.alamy.de/stockfoto-ol-verschmiert-auf-glas-mit-blauem-hintergrund-84883527.html
Öl verschmiert auf Glas mit blauem Hintergrund Stockfotohttps://www.alamy.de/image-license-details/?v=1https://www.alamy.de/stockfoto-ol-verschmiert-auf-glas-mit-blauem-hintergrund-84883527.htmlRFEX2NPF–Öl verschmiert auf Glas mit blauem Hintergrund
 Frost Muster auf der Glasscheibe Stockfotohttps://www.alamy.de/image-license-details/?v=1https://www.alamy.de/frost-muster-auf-der-glasscheibe-image221343537.html
Frost Muster auf der Glasscheibe Stockfotohttps://www.alamy.de/image-license-details/?v=1https://www.alamy.de/frost-muster-auf-der-glasscheibe-image221343537.htmlRMPT31X9–Frost Muster auf der Glasscheibe
 Abstraktes verschwommenes Bokeh auf Glashintergrund Stockfotohttps://www.alamy.de/image-license-details/?v=1https://www.alamy.de/abstraktes-verschwommenes-bokeh-auf-glashintergrund-image640069909.html
Abstraktes verschwommenes Bokeh auf Glashintergrund Stockfotohttps://www.alamy.de/image-license-details/?v=1https://www.alamy.de/abstraktes-verschwommenes-bokeh-auf-glashintergrund-image640069909.htmlRF2S59KKH–Abstraktes verschwommenes Bokeh auf Glashintergrund
 Schöne farbige Beugungseffekte von Wassertröpfchen auf Glas gegen Ein mehrfarbiger Hintergrund Stockfotohttps://www.alamy.de/image-license-details/?v=1https://www.alamy.de/schone-farbige-beugungseffekte-von-wassertropfchen-auf-glas-gegen-ein-mehrfarbiger-hintergrund-image425758690.html
Schöne farbige Beugungseffekte von Wassertröpfchen auf Glas gegen Ein mehrfarbiger Hintergrund Stockfotohttps://www.alamy.de/image-license-details/?v=1https://www.alamy.de/schone-farbige-beugungseffekte-von-wassertropfchen-auf-glas-gegen-ein-mehrfarbiger-hintergrund-image425758690.htmlRF2FMJYFE–Schöne farbige Beugungseffekte von Wassertröpfchen auf Glas gegen Ein mehrfarbiger Hintergrund
 Reflexion von Licht auf Glas Stockfotohttps://www.alamy.de/image-license-details/?v=1https://www.alamy.de/stockfoto-reflexion-von-licht-auf-glas-167209129.html
Reflexion von Licht auf Glas Stockfotohttps://www.alamy.de/image-license-details/?v=1https://www.alamy.de/stockfoto-reflexion-von-licht-auf-glas-167209129.htmlRFKM10XH–Reflexion von Licht auf Glas
 Regen fällt auf Glas Stockfotohttps://www.alamy.de/image-license-details/?v=1https://www.alamy.de/regen-fallt-auf-glas-image222300279.html
Regen fällt auf Glas Stockfotohttps://www.alamy.de/image-license-details/?v=1https://www.alamy.de/regen-fallt-auf-glas-image222300279.htmlRFPWJJ7K–Regen fällt auf Glas
 Herbstlaub auf Glas mit natürlichem Wassertropfen Stockfotohttps://www.alamy.de/image-license-details/?v=1https://www.alamy.de/stockfoto-herbstlaub-auf-glas-mit-naturlichem-wassertropfen-123555352.html
Herbstlaub auf Glas mit natürlichem Wassertropfen Stockfotohttps://www.alamy.de/image-license-details/?v=1https://www.alamy.de/stockfoto-herbstlaub-auf-glas-mit-naturlichem-wassertropfen-123555352.htmlRFH50C34–Herbstlaub auf Glas mit natürlichem Wassertropfen
 Wasser tropft auf Glas, viel Regen fällt auf das Fensterglas Stockfotohttps://www.alamy.de/image-license-details/?v=1https://www.alamy.de/wasser-tropft-auf-glas-viel-regen-fallt-auf-das-fensterglas-image361941844.html
Wasser tropft auf Glas, viel Regen fällt auf das Fensterglas Stockfotohttps://www.alamy.de/image-license-details/?v=1https://www.alamy.de/wasser-tropft-auf-glas-viel-regen-fallt-auf-das-fensterglas-image361941844.htmlRF2C0RTEC–Wasser tropft auf Glas, viel Regen fällt auf das Fensterglas
 Eicheln auf Glas jar über Holzoberfläche. Isoliert auf weißem Hintergrund Stockfotohttps://www.alamy.de/image-license-details/?v=1https://www.alamy.de/stockfoto-eicheln-auf-glas-jar-uber-holzoberflache-isoliert-auf-weissem-hintergrund-92478422.html
Eicheln auf Glas jar über Holzoberfläche. Isoliert auf weißem Hintergrund Stockfotohttps://www.alamy.de/image-license-details/?v=1https://www.alamy.de/stockfoto-eicheln-auf-glas-jar-uber-holzoberflache-isoliert-auf-weissem-hintergrund-92478422.htmlRFFACN4P–Eicheln auf Glas jar über Holzoberfläche. Isoliert auf weißem Hintergrund
 Topf gedünstet Schwein Tail auf Glas Essen Schrank bei Thai Indiomarkt Stockfotohttps://www.alamy.de/image-license-details/?v=1https://www.alamy.de/stockfoto-topf-gedunstet-schwein-tail-auf-glas-essen-schrank-bei-thai-indiomarkt-53180915.html
Topf gedünstet Schwein Tail auf Glas Essen Schrank bei Thai Indiomarkt Stockfotohttps://www.alamy.de/image-license-details/?v=1https://www.alamy.de/stockfoto-topf-gedunstet-schwein-tail-auf-glas-essen-schrank-bei-thai-indiomarkt-53180915.htmlRFD2EGPB–Topf gedünstet Schwein Tail auf Glas Essen Schrank bei Thai Indiomarkt
 Wassertröpfchen auf Glas und Blick auf die Landschaft, Tröpfchen auf Nahglas Stockfotohttps://www.alamy.de/image-license-details/?v=1https://www.alamy.de/wassertropfchen-auf-glas-und-blick-auf-die-landschaft-tropfchen-auf-nahglas-image402537836.html
Wassertröpfchen auf Glas und Blick auf die Landschaft, Tröpfchen auf Nahglas Stockfotohttps://www.alamy.de/image-license-details/?v=1https://www.alamy.de/wassertropfchen-auf-glas-und-blick-auf-die-landschaft-tropfchen-auf-nahglas-image402537836.htmlRF2EAW538–Wassertröpfchen auf Glas und Blick auf die Landschaft, Tröpfchen auf Nahglas
 Laptop auf Glastisch Stockfotohttps://www.alamy.de/image-license-details/?v=1https://www.alamy.de/stockfoto-laptop-auf-glastisch-92836213.html
Laptop auf Glastisch Stockfotohttps://www.alamy.de/image-license-details/?v=1https://www.alamy.de/stockfoto-laptop-auf-glastisch-92836213.htmlRFFB11F1–Laptop auf Glastisch
 Wasser auf Glasplatte, abstrakten Hintergrund Nahaufnahme Foto Stockfotohttps://www.alamy.de/image-license-details/?v=1https://www.alamy.de/wasser-auf-glasplatte-abstrakten-hintergrund-nahaufnahme-foto-image62512819.html
Wasser auf Glasplatte, abstrakten Hintergrund Nahaufnahme Foto Stockfotohttps://www.alamy.de/image-license-details/?v=1https://www.alamy.de/wasser-auf-glasplatte-abstrakten-hintergrund-nahaufnahme-foto-image62512819.htmlRFDHKKMK–Wasser auf Glasplatte, abstrakten Hintergrund Nahaufnahme Foto
 Textur des Eises auf Glas Stockfotohttps://www.alamy.de/image-license-details/?v=1https://www.alamy.de/textur-des-eises-auf-glas-image66462017.html
Textur des Eises auf Glas Stockfotohttps://www.alamy.de/image-license-details/?v=1https://www.alamy.de/textur-des-eises-auf-glas-image66462017.htmlRFDT3GYD–Textur des Eises auf Glas
 Geschäftsfrau Planungsstrategie an Glaswand mit Kollegen bei Creative Büro Stockfotohttps://www.alamy.de/image-license-details/?v=1https://www.alamy.de/geschaftsfrau-planungsstrategie-an-glaswand-mit-kollegen-bei-creative-buro-image389343016.html
Geschäftsfrau Planungsstrategie an Glaswand mit Kollegen bei Creative Büro Stockfotohttps://www.alamy.de/image-license-details/?v=1https://www.alamy.de/geschaftsfrau-planungsstrategie-an-glaswand-mit-kollegen-bei-creative-buro-image389343016.htmlRF2DHC2YM–Geschäftsfrau Planungsstrategie an Glaswand mit Kollegen bei Creative Büro
 Frau, die sich an die Glastür im Hinterhof lehnt Stockfotohttps://www.alamy.de/image-license-details/?v=1https://www.alamy.de/frau-die-sich-an-die-glastur-im-hinterhof-lehnt-image383342212.html
Frau, die sich an die Glastür im Hinterhof lehnt Stockfotohttps://www.alamy.de/image-license-details/?v=1https://www.alamy.de/frau-die-sich-an-die-glastur-im-hinterhof-lehnt-image383342212.htmlRF2D7JMW8–Frau, die sich an die Glastür im Hinterhof lehnt
 Wellenlinien auf Glas gedruckt, Detail der Bushaltestelle, Rio de Janeiro, Brasilien Stockfotohttps://www.alamy.de/image-license-details/?v=1https://www.alamy.de/wellenlinien-auf-glas-gedruckt-detail-der-bushaltestelle-rio-de-janeiro-brasilien-image683489180.html
Wellenlinien auf Glas gedruckt, Detail der Bushaltestelle, Rio de Janeiro, Brasilien Stockfotohttps://www.alamy.de/image-license-details/?v=1https://www.alamy.de/wellenlinien-auf-glas-gedruckt-detail-der-bushaltestelle-rio-de-janeiro-brasilien-image683489180.htmlRF3BKYHBT–Wellenlinien auf Glas gedruckt, Detail der Bushaltestelle, Rio de Janeiro, Brasilien
 Tropfen Sie Wasser für den Hintergrund auf Glas Autofenster zu abstrakten Design und Natur-Kulisse. Stockfotohttps://www.alamy.de/image-license-details/?v=1https://www.alamy.de/stockfoto-tropfen-sie-wasser-fur-den-hintergrund-auf-glas-autofenster-zu-abstrakten-design-und-natur-kulisse-113544641.html
Tropfen Sie Wasser für den Hintergrund auf Glas Autofenster zu abstrakten Design und Natur-Kulisse. Stockfotohttps://www.alamy.de/image-license-details/?v=1https://www.alamy.de/stockfoto-tropfen-sie-wasser-fur-den-hintergrund-auf-glas-autofenster-zu-abstrakten-design-und-natur-kulisse-113544641.htmlRFGGMB9N–Tropfen Sie Wasser für den Hintergrund auf Glas Autofenster zu abstrakten Design und Natur-Kulisse.
 Wassertropfen auf Glas Stockfotohttps://www.alamy.de/image-license-details/?v=1https://www.alamy.de/stockfoto-wassertropfen-auf-glas-82187121.html
Wassertropfen auf Glas Stockfotohttps://www.alamy.de/image-license-details/?v=1https://www.alamy.de/stockfoto-wassertropfen-auf-glas-82187121.htmlRFENKXE9–Wassertropfen auf Glas
 Öl verschmiert auf Glas mit blauem Hintergrund Stockfotohttps://www.alamy.de/image-license-details/?v=1https://www.alamy.de/stockfoto-ol-verschmiert-auf-glas-mit-blauem-hintergrund-84883326.html
Öl verschmiert auf Glas mit blauem Hintergrund Stockfotohttps://www.alamy.de/image-license-details/?v=1https://www.alamy.de/stockfoto-ol-verschmiert-auf-glas-mit-blauem-hintergrund-84883326.htmlRFEX2NFA–Öl verschmiert auf Glas mit blauem Hintergrund
 Baumfrosch, auf Glas sitzend, Hyla arborea, Hylidae, Bayern, Deutschland Stockfotohttps://www.alamy.de/image-license-details/?v=1https://www.alamy.de/baumfrosch-auf-glas-sitzend-hyla-arborea-hylidae-bayern-deutschland-image354851200.html
Baumfrosch, auf Glas sitzend, Hyla arborea, Hylidae, Bayern, Deutschland Stockfotohttps://www.alamy.de/image-license-details/?v=1https://www.alamy.de/baumfrosch-auf-glas-sitzend-hyla-arborea-hylidae-bayern-deutschland-image354851200.htmlRF2BH8T94–Baumfrosch, auf Glas sitzend, Hyla arborea, Hylidae, Bayern, Deutschland
 Abstraktes verschwommenes Bokeh auf Glashintergrund Stockfotohttps://www.alamy.de/image-license-details/?v=1https://www.alamy.de/abstraktes-verschwommenes-bokeh-auf-glashintergrund-image640069908.html
Abstraktes verschwommenes Bokeh auf Glashintergrund Stockfotohttps://www.alamy.de/image-license-details/?v=1https://www.alamy.de/abstraktes-verschwommenes-bokeh-auf-glashintergrund-image640069908.htmlRF2S59KKG–Abstraktes verschwommenes Bokeh auf Glashintergrund
 Schöne farbige Beugungseffekte von Wassertröpfchen auf Glas gegen Ein mehrfarbiger Hintergrund Stockfotohttps://www.alamy.de/image-license-details/?v=1https://www.alamy.de/schone-farbige-beugungseffekte-von-wassertropfchen-auf-glas-gegen-ein-mehrfarbiger-hintergrund-image425758697.html
Schöne farbige Beugungseffekte von Wassertröpfchen auf Glas gegen Ein mehrfarbiger Hintergrund Stockfotohttps://www.alamy.de/image-license-details/?v=1https://www.alamy.de/schone-farbige-beugungseffekte-von-wassertropfchen-auf-glas-gegen-ein-mehrfarbiger-hintergrund-image425758697.htmlRF2FMJYFN–Schöne farbige Beugungseffekte von Wassertröpfchen auf Glas gegen Ein mehrfarbiger Hintergrund
 Zigarre auf Glas Whiskey mit Eiswürfeln Stockfotohttps://www.alamy.de/image-license-details/?v=1https://www.alamy.de/stockfoto-zigarre-auf-glas-whiskey-mit-eiswurfeln-76799091.html
Zigarre auf Glas Whiskey mit Eiswürfeln Stockfotohttps://www.alamy.de/image-license-details/?v=1https://www.alamy.de/stockfoto-zigarre-auf-glas-whiskey-mit-eiswurfeln-76799091.htmlRFECXE0K–Zigarre auf Glas Whiskey mit Eiswürfeln
 Farbenfrohe restaurant Design auf Glas Fenster, Cambridge, England Stockfotohttps://www.alamy.de/image-license-details/?v=1https://www.alamy.de/farbenfrohe-restaurant-design-auf-glas-fenster-cambridge-england-image221055084.html
Farbenfrohe restaurant Design auf Glas Fenster, Cambridge, England Stockfotohttps://www.alamy.de/image-license-details/?v=1https://www.alamy.de/farbenfrohe-restaurant-design-auf-glas-fenster-cambridge-england-image221055084.htmlRMPRHX0C–Farbenfrohe restaurant Design auf Glas Fenster, Cambridge, England
 Geschäftsfrau mit Handy während stützte sich auf Glaswand Stockfotohttps://www.alamy.de/image-license-details/?v=1https://www.alamy.de/stockfoto-geschaftsfrau-mit-handy-wahrend-stutzte-sich-auf-glaswand-84546903.html
Geschäftsfrau mit Handy während stützte sich auf Glaswand Stockfotohttps://www.alamy.de/image-license-details/?v=1https://www.alamy.de/stockfoto-geschaftsfrau-mit-handy-wahrend-stutzte-sich-auf-glaswand-84546903.htmlRFEWFCC7–Geschäftsfrau mit Handy während stützte sich auf Glaswand
 Paar schreiben Namensliste auf Glas Stockfotohttps://www.alamy.de/image-license-details/?v=1https://www.alamy.de/stockfoto-paar-schreiben-namensliste-auf-glas-59054565.html
Paar schreiben Namensliste auf Glas Stockfotohttps://www.alamy.de/image-license-details/?v=1https://www.alamy.de/stockfoto-paar-schreiben-namensliste-auf-glas-59054565.htmlRFDC24KH–Paar schreiben Namensliste auf Glas
 Walnüsse auf Glas jar über Holzoberfläche. Isoliert auf weißem Hintergrund Stockfotohttps://www.alamy.de/image-license-details/?v=1https://www.alamy.de/stockfoto-walnusse-auf-glas-jar-uber-holzoberflache-isoliert-auf-weissem-hintergrund-92478419.html
Walnüsse auf Glas jar über Holzoberfläche. Isoliert auf weißem Hintergrund Stockfotohttps://www.alamy.de/image-license-details/?v=1https://www.alamy.de/stockfoto-walnusse-auf-glas-jar-uber-holzoberflache-isoliert-auf-weissem-hintergrund-92478419.htmlRFFACN4K–Walnüsse auf Glas jar über Holzoberfläche. Isoliert auf weißem Hintergrund
 Geschäftsfrau Haftnotizen auf Glas mit Kollegen im Hintergrund lesen Stockfotohttps://www.alamy.de/image-license-details/?v=1https://www.alamy.de/stockfoto-geschaftsfrau-haftnotizen-auf-glas-mit-kollegen-im-hintergrund-lesen-74800931.html
Geschäftsfrau Haftnotizen auf Glas mit Kollegen im Hintergrund lesen Stockfotohttps://www.alamy.de/image-license-details/?v=1https://www.alamy.de/stockfoto-geschaftsfrau-haftnotizen-auf-glas-mit-kollegen-im-hintergrund-lesen-74800931.htmlRFE9KD9R–Geschäftsfrau Haftnotizen auf Glas mit Kollegen im Hintergrund lesen
 Wassertröpfchen auf Glas und Blick auf die Landschaft, Tröpfchen auf Nahglas Stockfotohttps://www.alamy.de/image-license-details/?v=1https://www.alamy.de/wassertropfchen-auf-glas-und-blick-auf-die-landschaft-tropfchen-auf-nahglas-image402537795.html
Wassertröpfchen auf Glas und Blick auf die Landschaft, Tröpfchen auf Nahglas Stockfotohttps://www.alamy.de/image-license-details/?v=1https://www.alamy.de/wassertropfchen-auf-glas-und-blick-auf-die-landschaft-tropfchen-auf-nahglas-image402537795.htmlRF2EAW51R–Wassertröpfchen auf Glas und Blick auf die Landschaft, Tröpfchen auf Nahglas
 Geringen Teil der junge Frau lehnt sich an Glaswand Stockfotohttps://www.alamy.de/image-license-details/?v=1https://www.alamy.de/stockfoto-geringen-teil-der-junge-frau-lehnt-sich-an-glaswand-132930404.html
Geringen Teil der junge Frau lehnt sich an Glaswand Stockfotohttps://www.alamy.de/image-license-details/?v=1https://www.alamy.de/stockfoto-geringen-teil-der-junge-frau-lehnt-sich-an-glaswand-132930404.htmlRFHM7E2C–Geringen Teil der junge Frau lehnt sich an Glaswand
 Wasser auf Glasplatte, abstrakten Hintergrund Nahaufnahme Foto Stockfotohttps://www.alamy.de/image-license-details/?v=1https://www.alamy.de/wasser-auf-glasplatte-abstrakten-hintergrund-nahaufnahme-foto-image62512956.html
Wasser auf Glasplatte, abstrakten Hintergrund Nahaufnahme Foto Stockfotohttps://www.alamy.de/image-license-details/?v=1https://www.alamy.de/wasser-auf-glasplatte-abstrakten-hintergrund-nahaufnahme-foto-image62512956.htmlRFDHKKWG–Wasser auf Glasplatte, abstrakten Hintergrund Nahaufnahme Foto
 Geschäftsfrauen Haftnotizen auf Glaswand in Kreativbüro lesen Stockfotohttps://www.alamy.de/image-license-details/?v=1https://www.alamy.de/stockfoto-geschaftsfrauen-haftnotizen-auf-glaswand-in-kreativburo-lesen-74798140.html
Geschäftsfrauen Haftnotizen auf Glaswand in Kreativbüro lesen Stockfotohttps://www.alamy.de/image-license-details/?v=1https://www.alamy.de/stockfoto-geschaftsfrauen-haftnotizen-auf-glaswand-in-kreativburo-lesen-74798140.htmlRFE9K9P4–Geschäftsfrauen Haftnotizen auf Glaswand in Kreativbüro lesen
 Geschäftsmann, der mit dem Smartphone spricht, während er sich auf der Straße an eine Glastür lehnt Stockfotohttps://www.alamy.de/image-license-details/?v=1https://www.alamy.de/geschaftsmann-der-mit-dem-smartphone-spricht-wahrend-er-sich-auf-der-strasse-an-eine-glastur-lehnt-image590651569.html
Geschäftsmann, der mit dem Smartphone spricht, während er sich auf der Straße an eine Glastür lehnt Stockfotohttps://www.alamy.de/image-license-details/?v=1https://www.alamy.de/geschaftsmann-der-mit-dem-smartphone-spricht-wahrend-er-sich-auf-der-strasse-an-eine-glastur-lehnt-image590651569.htmlRF2W8XE2W–Geschäftsmann, der mit dem Smartphone spricht, während er sich auf der Straße an eine Glastür lehnt
 Porträt einer hübschen Frau, die sich an einer Glaswand lehnt Stockfotohttps://www.alamy.de/image-license-details/?v=1https://www.alamy.de/portrat-einer-hubschen-frau-die-sich-an-einer-glaswand-lehnt-image354710727.html
Porträt einer hübschen Frau, die sich an einer Glaswand lehnt Stockfotohttps://www.alamy.de/image-license-details/?v=1https://www.alamy.de/portrat-einer-hubschen-frau-die-sich-an-einer-glaswand-lehnt-image354710727.htmlRF2BH2D47–Porträt einer hübschen Frau, die sich an einer Glaswand lehnt
 Junger Geschäftsmann klebrigen Papier an Glaswand an Kreativbüro lesen Stockfotohttps://www.alamy.de/image-license-details/?v=1https://www.alamy.de/stockfoto-junger-geschaftsmann-klebrigen-papier-an-glaswand-an-kreativburo-lesen-74800688.html
Junger Geschäftsmann klebrigen Papier an Glaswand an Kreativbüro lesen Stockfotohttps://www.alamy.de/image-license-details/?v=1https://www.alamy.de/stockfoto-junger-geschaftsmann-klebrigen-papier-an-glaswand-an-kreativburo-lesen-74800688.htmlRFE9KD14–Junger Geschäftsmann klebrigen Papier an Glaswand an Kreativbüro lesen
 Tropfen Sie Wasser für den Hintergrund auf Glas Autofenster zu abstrakten Design und Natur-Kulisse. Stockfotohttps://www.alamy.de/image-license-details/?v=1https://www.alamy.de/stockfoto-tropfen-sie-wasser-fur-den-hintergrund-auf-glas-autofenster-zu-abstrakten-design-und-natur-kulisse-113544655.html
Tropfen Sie Wasser für den Hintergrund auf Glas Autofenster zu abstrakten Design und Natur-Kulisse. Stockfotohttps://www.alamy.de/image-license-details/?v=1https://www.alamy.de/stockfoto-tropfen-sie-wasser-fur-den-hintergrund-auf-glas-autofenster-zu-abstrakten-design-und-natur-kulisse-113544655.htmlRFGGMBA7–Tropfen Sie Wasser für den Hintergrund auf Glas Autofenster zu abstrakten Design und Natur-Kulisse.
 Wassertropfen auf Glas Stockfotohttps://www.alamy.de/image-license-details/?v=1https://www.alamy.de/stockfoto-wassertropfen-auf-glas-82187116.html
Wassertropfen auf Glas Stockfotohttps://www.alamy.de/image-license-details/?v=1https://www.alamy.de/stockfoto-wassertropfen-auf-glas-82187116.htmlRFENKXE4–Wassertropfen auf Glas
 Frau kleben Klebeband auf Glas Fenster Stockfotohttps://www.alamy.de/image-license-details/?v=1https://www.alamy.de/frau-kleben-klebeband-auf-glas-fenster-image217396539.html
Frau kleben Klebeband auf Glas Fenster Stockfotohttps://www.alamy.de/image-license-details/?v=1https://www.alamy.de/frau-kleben-klebeband-auf-glas-fenster-image217396539.htmlRFPHK7E3–Frau kleben Klebeband auf Glas Fenster
 Stinkender Käfer krabbelt auf der Glasoberfläche. Grüner Hintergrund mit Kopierbereich. Stockfotohttps://www.alamy.de/image-license-details/?v=1https://www.alamy.de/stinkender-kafer-krabbelt-auf-der-glasoberflache-gruner-hintergrund-mit-kopierbereich-image654832276.html
Stinkender Käfer krabbelt auf der Glasoberfläche. Grüner Hintergrund mit Kopierbereich. Stockfotohttps://www.alamy.de/image-license-details/?v=1https://www.alamy.de/stinkender-kafer-krabbelt-auf-der-glasoberflache-gruner-hintergrund-mit-kopierbereich-image654832276.htmlRF3A1A570–Stinkender Käfer krabbelt auf der Glasoberfläche. Grüner Hintergrund mit Kopierbereich.
 Abstraktes verschwommenes Bokeh auf Glashintergrund Stockfotohttps://www.alamy.de/image-license-details/?v=1https://www.alamy.de/abstraktes-verschwommenes-bokeh-auf-glashintergrund-image640069907.html
Abstraktes verschwommenes Bokeh auf Glashintergrund Stockfotohttps://www.alamy.de/image-license-details/?v=1https://www.alamy.de/abstraktes-verschwommenes-bokeh-auf-glashintergrund-image640069907.htmlRF2S59KKF–Abstraktes verschwommenes Bokeh auf Glashintergrund
 Schöne farbige Beugungseffekte von Wassertröpfchen auf Glas gegen Ein mehrfarbiger Hintergrund Stockfotohttps://www.alamy.de/image-license-details/?v=1https://www.alamy.de/schone-farbige-beugungseffekte-von-wassertropfchen-auf-glas-gegen-ein-mehrfarbiger-hintergrund-image428750003.html
Schöne farbige Beugungseffekte von Wassertröpfchen auf Glas gegen Ein mehrfarbiger Hintergrund Stockfotohttps://www.alamy.de/image-license-details/?v=1https://www.alamy.de/schone-farbige-beugungseffekte-von-wassertropfchen-auf-glas-gegen-ein-mehrfarbiger-hintergrund-image428750003.htmlRF2FWF703–Schöne farbige Beugungseffekte von Wassertröpfchen auf Glas gegen Ein mehrfarbiger Hintergrund

